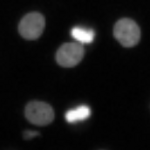
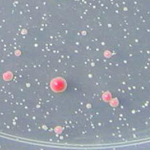

OLD CellProfiler example images and pipelines (Prior to 4.0)
These examples are outdated, please see our current Examples page for the updated versions.
Basic Pipelines
Specialized Pipelines
- Cell/particle counting and scoring the percentage of stained objects
- Yeast colony classification
- Yeast patch identification
- Tissue Neighbors
- Wound Healing
- Illumination Correction
- Colocalization
- Spot Detection, for beginners
WormToolbox Pipelines
- Untangle worms
- Straighten worms and extract intensity measurements using a low-resolution atlas
- Create your own worm model
- Untangle worms and make measurements bright-field staining pattern phenotype
More Advanced Pipelines
- Human cytoplasm-nucleus translocation assay (SBS Vitra)
- Human cytoplasm-nucleus translocation assay (SBS Bioimage)
- Speckle Counting
- Object Tracking and Metadata Management
- Sequencing RNA molecules in situ combining CellProfiler with ImageJ plugins
File Utilities
Published Pipelines
Basic Pipelines
These pipelines are made for simple cellular and tissue image assays, and include some basic measurements.
Human cells


Human HT29 cells are fairly smooth and elliptical. This pipeline demonstrates how to accurately identify these cells and how to measurements cellular parameters such as morphology, count, intensity and texture.
Download (0.3 MB)
Fruit fly cells


In contrast to the HT29 cells, Drosophila Kc167 cells are a highly textured and clumpy cell type. This pipeline demonstrates how to identify these clumpy cells and obtain morphological, intensity and texture measurements.
Download (4 MB)
Tumors


A simple pipeline that identifies and counts tumors in a mouse lung, and then measures their size.
Download (0.9 MB)
Comet assay


This is a simple example of a DNA damage assay using single cell gel electrophoresis. Here, the measurement of interest is the length and intensity of the comet tail. Also, illumination correction is used to reduce background fluorescence prior to measurement. Also shown is a silver-stained comet example in which the percentage of DNA contained in the tail is calculated.
Download (0.4 MB)
Specialized Pipelines
In addition to cellular object and feature identification, these pipelines include some of the more specialized modules in CellProfiler for image pre-processing or measurement.
Cell/particle counting and scoring the percentage of stained objects

CellProfiler is commonly used to count cells or other objects as well as percent-positives, by measuring the per-cell staining intensity. This pipeline shows how to do both of these tasks, and demonstrates how various modules may be used to accomplish the same result.
Download (0.2 MB)
Yeast colony classification

This pipeline demonstrates how to classify and count objects on the basis of their measured features. The example identifies uniformly round objects, in this case, yeast colonies growing on a dish. The pipeline also shows how to load a template and align it to a cropped image, as well as how to use illumination correction to subtract for background illumination.
Download (0.6 MB)
Yeast patch identification


This pipeline identifies patches of yeast growing in a 96 well plate, serving as an introduction to the grid defintion and identification modules.
Download (0.4 MB)
Tissue Neighbors


Tissue samples often have irregularly shaped cells with adjacent edges. This pipeline shows how to input a color tissue image, split it into its component channels, and then identify individual cells from a particular stain and record the number of neighbors that each cell has.
Download (0.1 MB)
Wound Healing


In this example, cells are grown as a tissue monolayer. Rather than identifying individual cells, this pipeline quantifies the area occupied by the tissue sample.
Download (1.1 MB)
Illumination Correction


Illumination correction is often important for both accurate segmentation and for intensity measurements. This example shows how the CorrectIlluminationCalculate and CorrectIlluminationApply modules are used to compensate for the non-uniformities in illumination often present in microscopy images.
Download (17.6 MB)
Colocalization


Measuring the colocalization between fluorescently labeled molecules is a widely used approach to measure the degree of spatial coincidence and potential interactions among subcellular species (e.g., proteins). This example shows how the object identifcation and RelateObjects modules are used to measure the degree of overlap between two fluorescent channels.
Download (3.7 MB)
Spot Detection, for beginners


In this practical you will learn how to set up an automated CellProfiler image analysis pipeline that will (1) identify individual cells in images, based on a nuclear stain, (2) identify dot-like signals, and (3) count the number of dots per cell and output this information to a spreadsheet. This quantification will enable you to compare the number of dots per cell in wild-type and mutant conditions as well as to measure how the number of dots per cell depends on primary antibody concentration.
Download (1.5 MB)
Imaging Flow Cytometry
Imaging flow cytometry combines the high-throughput capabilities of conventional flow cytometry with single-cell imaging. CellProfiler can be used to analyze the resulting images from imaging flow cytometry, whether brightfield, darkfield, or fluorescence.
Worm Toolbox
These pipelines have been developed for high-throughput screens on C. elegans and extract measurements on a per-worm basis. The Worm Toolbox page has further details on this workflow, as well as video tutorials, pipelines and image data in addition to those described below. (from C Wählby et al. Methods, 2014) The BBBC also has C. elegans sample images and information, as well as assay "ground truth" of various kinds.
Untangle worms


In this pipeline, we identify individual worms and extract shape and intensity measurements. Worm untangling requires a worm model, which is provided together with the pipeline. If adjusting the pipeline to fit your own data, worm detection will likely improve by creating a new worm model based on your own image data.
Download (1.3 MB)
Straighten worms and extract intensity measurements using a low-resolution atlas


Once worms are untangled, this pipeline shows how they can be straightened and aligned with a low-resolution worm atlas to extract localized intensity measurements and compare patterns of reporter signals. Included are steps for identifying secondary objects (fluorescent marker signals) and relating these objects to individual worms, enabling count of signals on a per-worm basis.
Download (968 KB)
Create your own worm model


The UntangleWorms module has an "Untangle" mode and a "Train" mode. This pipeline describes how the "Train" mode is used to create a worm model. Training consists of providing a large number of images of worms that are representative of the worm variation within the population, and that do not touch or overlap. Note that this example download includes only two images and will not result in a good model, as it will not be representative of all possible variations of the worm shapes. We recommend using at least 60 worms to create a model.
Download (1.6 MB)
Untangle worms and make measurements bright-field staining pattern phenotype


This pipeline detects individual worms by worm untangling and finds sub-objects (fatty regions stained with oil red O) within the worms. Using bright-field data only, it detects fatty regions by intensity thresholding in a single image channel and relates the fatty regions to individual worms. This enables detection of rare phenotypes in heterogeneous populations, phenotypes that would be missed if population averages were observed. More data can be found on the BBBC.
Download (852 KB)
More Advanced Pipelines
These pipelines are more complex in terms in image processing, feature identification and the desired measurements.
Human cytoplasm-nucleus translocation assay (SBS Vitra)


In this human cytoplasm-nucleus translocation assay, learn how to load a previously calculated illumination correction function for two separate channels, measure protein content in the nucleus and cytoplasm, and calculate the ratio as a measure of translocation. This is a clumpy cell type, so studying the settings in primary object identification may be helpful for users interested in the more advanced options that module offers. More about these images can be found at the BBBC.
Download (13 MB)
Human cytoplasm-nucleus translocation assay (SBS Bioimage)


This example includes an advanced example of illumination correction - creating an illumination correction function from all images in a 96-well plate. This pipeline also demonstrates how to load dosage information via the LoadData module, how to use advanced methods for primary and seecondary object identifcation, and how to calculate the Z' factor, a measure of assay quality. More about these images can be found at the BBBC.
Download (40 MB)
Speckle Counting


This pipeline shows how to identify smaller objects (foci) within larger objects (nuclei) and how to use the Relate module to establish a relationship between the two as well as perform per-object aggregate measurements (such as number of foci per nucleus).
Download (3 MB)
Object Tracking and Metadata Management


This example shows an example of object tracking. This pipeline analyzes a time-lapse experiment to identify the cells and track them from frame to frame, which is challenging since the cells are also moving. In addition, this pipeline also extracts metadata from the filename and uses groups the images by metadata in order to independently process several sequences of images and output the measurements of each.
Download (10 MB)
Sequencing RNA molecules in situ combining CellProfiler with ImageJ plugins.


Some image analysis algorithms, such as more advanced image alignment, are not available in CellProfiler. However, functions available as ImageJ plugins can be called from CellProfiler. This pipeline shows how images from subsequent base-calling cycles can be aligned using ImageJ plugins from for RNA sequencing in situ. Sequencing substrates are generated using gap-fill padlock probes and rolling circle amplification, followed by the sequencing-by-ligation chemistry (Ke et al, In situ sequencing for RNA analysis in preserved tissue and cells, Nature Methods, published online July 14, 2013, https://doi.org/10.1038/nmeth.2563). Note that additional ImageJ plugins are required and can be downloaded as described in the included README file. MATLAB scripts for sequence visualization are also included in the ZIP file.
Download (45 MB)
File Utilities
These pipelines show examples of file display and format manipulation.
Invert for Printing


Inverts RGB fluorescence microscopy images from a black background to a white background.
Download (0.2 MB)
Color To Gray


Demonstrates how to separate a color image image into its component channels, and how to combine grayscale channel images into an RGB color image.
Download (0.8 MB)
Convert Image File Format

Loads image and saves them in a different file format.
Download (0.9 MB)
Published Pipelines
Pipelines which have appeared in published papers are provided here. Please keep in mind that the listed pipelines are specific to the published assay and that no images are provided.
